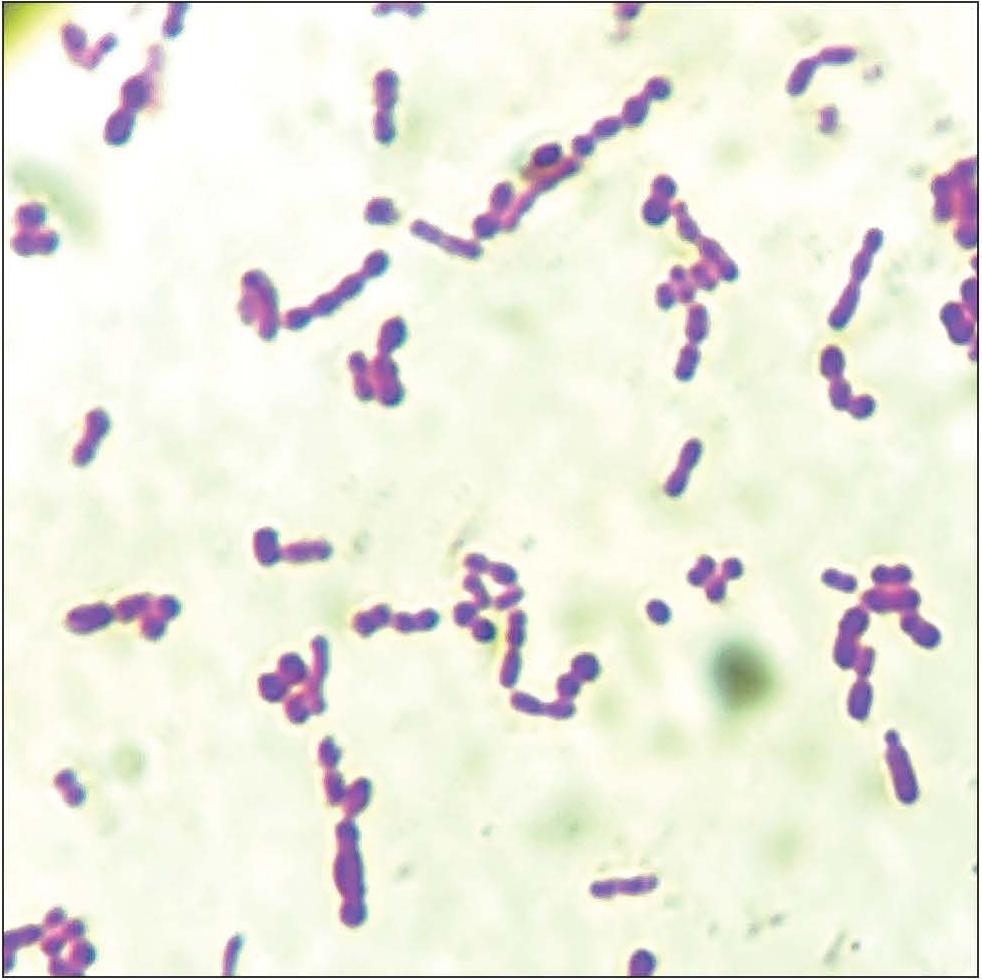
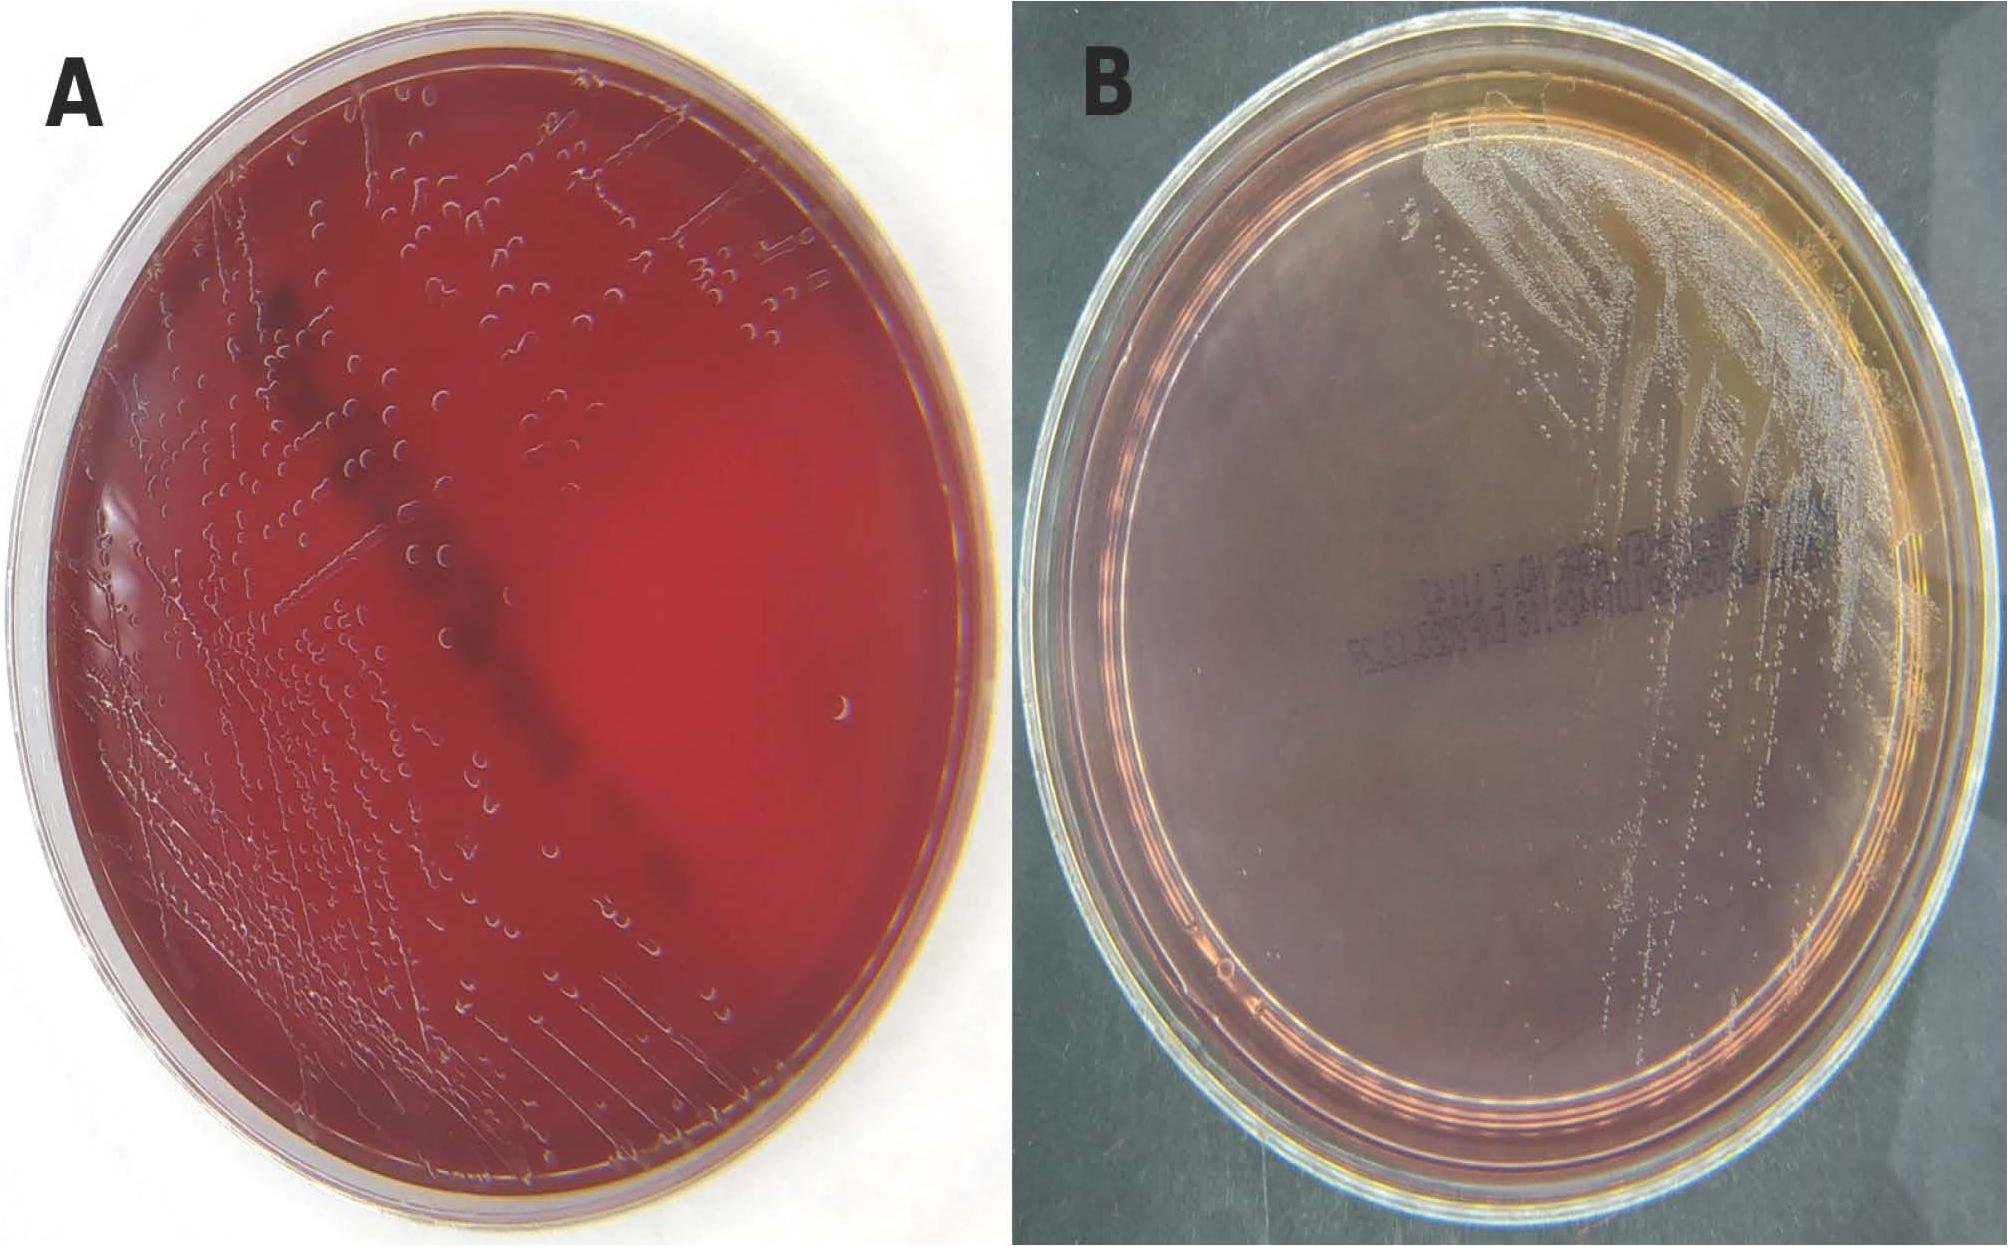

Sepsis and pneumonia are life-threatening infections, especially in immunocompromised patients with related disorders (Signe et al. 2012; Kreitmann et al. 2024). Although the main causative agents of these conditions are well known, the emergence of new and rare pathogens has created new challenges in the clinical setting (Wirth et al. 2012).
Psychrobacter sanguinis (P sanguinis), a Gram-negative, non-motile coccobacillus, is mainly associated with cold environments and was first isolated from marine and extreme habitats. The Psychrobacter genus, a member of the Moraxellaceae family, includes various species that are resistant to low temperatures and display unique metabolic adaptations that help them survive in harsh environmental conditions (Ioannou et al. 2025). These coccobacilli are psychrophilic to psychrotolerant, halotolerant, and aerobic, capable of growing in environments with moderate to high salinity, at temperatures between 10°C and 12°C, and at pH levels from 6 to 8 (Irlinger et al. 2012; Welter et al. 2021). However, strains of Psychrobacter faecalis (P. faecalis) and Psychrobacterpulmonis (P. pulmonis), isolated from warm-blooded anim nals such as pigeons and lambs, can grow at 36-37°C (Kämpfer et al. 2002; Vela et al. 2003). Though infections caused by Psychrobacter species are still rare, they are increasingly reported in hospital settings, especially in patients with weakened immune systems. Recent studies and clinical observations indicate that P sanguinis may have a potential pathogenic role in humans, capable of causing opportunistic infections. The isolation of P. sanguinis from clinical samples underscores its potential to cause severe infections, including sepsis, pneumonia, and meningitis (Lloyd-Puryear et al. 1991; Le Guern et al. 2014). Its pathogenicity and resistance mechanisms are still not yet fully understood due to the organism’s recent discovery. Nevertheless, molecular identification techniques such as 16S rRNA sequencing and MALDI-TOF mass spectrometry (matrix-assisted laser desorption/ionization time-of-flight) are vital for accurate detection. Further research is needed to clarify the clinical importance of P. sanguinis, especially for immunocompromised individuals or those with open wounds exposed to aquatic environments (Wirth et al. 2012; Ortiz-Alcántara et al. 2016; Bonwitt et al. 2018).
This study aimed to describe the presence of P sanguinis in patients diagnosed with sepsis and pneumonia at the District Hospital in Limanowa, named after Divine Mercy. We aim to enhance understanding of the clinical importance of this emerging pathogen and address the diagnostic and treatment challenges it presents by characterizing the isolates and analyzing their antimicrobial resistance profiles.
This study focused on two P. sanguinis strains isolated from patients hospitalized at the District Hospital in Liman owa, southern Poland. Both strains were obtained from blood samples. The isolates came from separate patients admitted to different hospital units, and both patients met the septic shock criteria according to the Quick Sequential Organ Failure Assessment (qSOFA) score. Detailed information about P. sanguinis strains PS12844 and PS1501 is provided in Table 1.
Characteristics of Psychrobacter sanguinis strains isolated in the District Hospital in Limanowa, named after Divine Mercy.
| Strain No. | Date of isolation | Site of isolation | Unit | Sex/Age |
|---|---|---|---|---|
| PS12844 | 21.11.2023 | blood | ICUa | M/39 |
| PS1501 | 28.01.2024 | blood | IMUa | M/72 |
ICU – Anesthesiology and Intensive Care Unit, IMU – Internal Medicine Unit
The first isolate, PS12844, was derived from a 39-year-old male patient with a history of alcohol use disorder (AUD) who developed multi-organ failure due to aspiration pneumonia. The patient was admitted to the Anesthesiology and Intensive Care Unit (ICU) on November 15, 2023, because of severe respiratory distress. The patient stayed in the hospital for eight days, and died on November 23, 2023.
The second isolate, PS1501, was obtained from a 72-year-old male patient with AUD who was hospitalized in the Internal Medicine Unit (IMU) for acute kidney injury (AKI) caused by benign prostatic hyperplasia (BPH). The patient was admitted to the ward on January 24, 2024, and received 36 days of treatment. On February 29, 2024, he was transferred to a specialized hospital for urological surgical intervention.
Blood cultures were collected on the first day of hospitalization using the BacT/ALERT blood culture system (BioMérieux, Marcy-l’Étoile, France) under both aerobic and anaerobic conditions. Psychrobacter sanguinis was isolated from a single aerobic blood culture in each instance. Co-isolation of Staphylococcus epidermidis, either alone or with Staphylococcus capitis, was observed in aerobic cultures, and these staphylococcal species were also found in the corresponding anaerobic cultures from the same blood culture sets.
The heat-fixed blood smears, as well as smears prepared from cultures on Columbia agar with 5% horse blood (Oxoid Ltd., Hampshire, United Kingdom), were stained using the Gram method in an automated staining instrument (RAL Stainer, Argenta Ltd., Poznan, Poland).
The tested strains were inoculated onto Columbia agar with 5% horse blood (Oxoid Ltd., Hampshire, United Kingdom), MacConkey agar (Oxoid Ltd., Hampshire, United Kingdom), and chocolate agar (Oxoid Ltd., Hampshire, United Kingdom), and incubated at 35°C for 18 ± 2 hours under aerobic conditions.
VITEK® 2 Compact (BioMérieux, Marcy-l’Étoile, France) was used with the ID-GN card to identify Gram-negative rods. The identification cards feature 64 wells with 41 fluorescent biochemical tests, including 18 enzymatic tests for aminopeptidases and oxidases, 18 fermentation tests, and three miscellaneous tests.
Bacterial colonies grown on Columbia agar with 5% horse blood were suspended in sterile 0.45% sodium chloride solution and adjusted to a 0.5 McFarland standard using the DensiChek Densitometer (BioMérieux, Marcy-l’Étoile, France). The inoculated tubes and ID cards were placed in a cassette and inserted into the VITEK® 2 Compact instrument. The card inoculation process was automatically performed inside the instrument.
Results from the VITEK® 2 Compact system are interpreted using the database, with a confidence value classified as excellent, very good, good, acceptable, low discrimination (when more than one ID result was provided), inconclusive, or unidentified.
BD Phoenix™ automated identification and susceptibility testing system (Becton Dickinson, Erem-bodegem, Belgium). Identification was performed using combined ID and AST NMIC/ID 14 panels for Gram-negative bacilli, which analyze 20 enzymatic reactions, 16 carbohydrates, seven other carbon sources, and resistance to two antibiotics (colistin and polymyxin B).
The ID broth (Becton Dickinson, Erembodegem, Belgium) was inoculated with bacterial colonies from Columbia blood agar and adjusted to a 0.5 to 0.6 McFarland standard using the Crystal Spec Nephelometer (Becton Dickinson, Erembodegem, Belgium), following the manufacturer’s instructions (O’Hara 2005). Next, 25 μL of ID broth was transferred to AST broth, which was supplemented with one drop of indicator dye (Becton Dickinson, Erembodegem, Belgium). The ID and AST broths were then poured into panels, sealed, and placed in the BD Phoenix™ instrument within 30 minutes of inoculation. Species or group identification results obtained with the BD Phoenix™ instrument are reported when the confidence level exceeds 90%.
The isolates were also identified using mass spectrometry (MALDI-TOF MS, Bruker Daltonics, and the IVD/12/11758 database). MALDI-TOF target plates were inoculated at specific spots by picking a freshly grown overnight colony, and after drying, 1 μl of matrix solution (α-cyano-4-hydroxycinnamic acid in 50% acetonitrile and 2.5% TFA) was applied. The results were interpreted based on the scoring system recommended by the manufacturer: a score value ≤2.0 indicates species-level identification, a score between 1.7 and 1.99 indicates genus-level identification, and scores <1.7 indicate no reliable identification.
Antimicrobial susceptibility testing was performed using the Etest method (BioMérieux, Marcy-l’Étoile, France). A bacterial suspension with a turbidity of 0.5 McFarland was prepared from an overnight culture grown on Columbia agar (Oxoid Ltd., Hampshire, United Kingdom) and used to inoculate Mueller-Hinton agar with horse blood (Oxoid Ltd., Hampshire, United Kingdom). Plates were incubated at 35°C for 18 ± 2 hours under aerobic conditions. The MIC values were interpreted based on the EUCAST guidelines for aerobic Gram-negative bacteria, despite the lack of established clinical breakpoints (EUCAST 2024). The microbiological activity of the antimicrobial agents was evaluated by comparing the MICs obtained to EUCAST-recommended reference values. Agents with MIC values above the recommended thresholds were deemed unsuitable for clinical use, while those with MIC values equal to or below the reference values were considered potentially effective for treatment.
Both isolates (PS12844 and PS1501) were successfully identified as P. sanguinis through conventional and molecular methods.
Gram staining of blood smears showed a high concentration of Gram-positive cocci, along with Gram-variable coccobacilli, which were later identified as P. sanguinis. Gram staining of a culture smear revealed many Gram-variable coccobacilli (Fig. 1).
Microscopic morphology of P. sanguinis (Gram stain, x1000) (ECLIPSE E200 optical microscope, Nikon Instruments Inc., Melville, NY, USA).
Cultures incubated at 35°C for 18 ± 2 hours yielded medium-sized, non-pigmented, non-hemolytic, shiny (water-like shine) colonies on Colombia agar with 5% horse blood (Oxoid Ltd., Hampshire, United Kingdom) and on chocolate agar (Oxoid Ltd., Hampshire, United Kingdom). Additionally, small colonies with the same appearance formed on MacConkey agar (Oxoid Ltd., Hampshire, United Kingdom).
Following subculture at 35°C, both isolates formed medium-sized, non-pigmented, non-hemolytic colonies with a smooth, water-like sheen on Colombia agar with 5% horse blood and chocolate agar. Smaller colonies of similar appearance were observed on MacConkey agar (Fig. 2). No bacterial growth was detected at higher temperatures, consistent with the psychrotolerant nature of Psychrobacter spp.
Morphology of Psychrobacter sanguinis colonies on Colombia agar with 5% horse blood (Oxoid Ltd., Hampshire, United Kingdom) (A) and MacConkey agar (Oxoid Ltd., Hampshire, United Kingdom) (B) after incubation by 18±2 hours in aerobic condition at 35°C.
Both PS12844 and PS 1051 Psychrobacter strains were identified by the VITEK® 2 Compact system (BioMérieux, Marcy-IÉtoile, France) with low confidence as members of the Moraxella group, based on positive reactions for tyrosine arylamidase, lipase, and urease. Acinetobacter Iwoffii was a potentially distinguishable microorganism (Supplementary file, Table 1).
The BD Phoenix™ system (Becton Dickinson, Erembodegem, Belgium) identified strain PS12844 as Moraxella spp. based on positive reactions in enzymatic hydrolysis of the following amides: L-glutamic acid, L-arginine, glycine, L-leucine, gamma-L-glutamyl; utilization of a carbon from alpha-ketoglutaric acid; and urea hydrolysis. In contrast, strain PS1051 was not identified (Supplementary file, Table 2).
BLAST results for consensus sequences obtained in this study from Psychrobacter sanguinis st rains.
| Strain | Sequence | Genotypic species identification | 16S rRNA gene seq. Similarity (%) | Closest relative reference strain in BLAST |
|---|---|---|---|---|
| PS12844 | Psychrobacter sanguinis strain JM50 16S ribosomal RNA gene, partial sequence | P. sanguinis | 100.00% | MN758810.1 |
| PS12844 | Psychrobacter sanguinis strain N8K9ELMT 16S ribosomal RNA gene, partial sequence | P. sanguinis | 100.00% | MH178035.1 |
| PS12844 | Psychrobacter sanguinis strain CNM637-12 16S ribosomal RNA gene, partial sequence | P. sanguinis | 100.00% | KR232929.1 |
| PS1051 | Psychrobacter sanguinis strain JM50 16S ribosomal RNA gene, partial sequence | P. sanguinis | 99.71% | MN758810.1 |
| PS1051 | Psychrobacter sanguinis strain N8K9ELMT 16S ribosomal RNA gene, partial sequence | P. sanguinis | 99.71% | MH178035.1 |
Both isolates were successfully identified at the species level by MALDI-TOF MS as Psychrobacter sanguinis, with scores of 2.38 and 2.41 for PS12844 and PS1051, respectively. Analysis of the MALDI-TOF MS results did not indicate any other species in its database that could be mistaken for Psychrobacter sanguinis. To confirm the species identity, 16S rRNA gene sequencing was performed by Genomed (Warsaw, Poland). The sequencing results supported the MALDI-TOF MS identification, confirming both isolates as Psychrobacter sanguinis. The sequences obtained were analyzed using the BLAST program at the NCBI website’s GenBank and showed 99.71-100% similarity to P. sanguinis reference sequences deposited in GenBank (Table 2).
These results confirmed the taxonomic identity of both isolates as P sanguinis. Comparison of consensus 16S rRNA gene sequences between the two isolates (PS12844 and PS1051) showed a high degree of similarity, with 99.71% identity. These findings verify that both isolates are from the same species, P. sanguinis, while also indicating minor sequence variations, which may reflect intraspecies diversity.
The obtained sequences have been submitted to GenBank (accession number SUB15468073).
The MIC values of six antimicrobial agents for Psychrobacter sanguinis strains PS12844 and PS1051 were compared with the interpretive thresholds proposed for aerobic Gram-negative bacteria in the EUCAST guidance document “What to do when there are no breakpoints” (version dated September 3, 2024). This document provides recommendations for situations where species- or agent-specific clinical breakpoints are unavailable, relying on pharmacokinetic/pharmacodynamic (PK/PD) non-species-related breakpoints or epidemiological cut-off values (ECOFFs). According to the guidance, when a dash (“-”) appears in the EU-CAST tables, the agent should be considered unsuitable for clinical use against the organism. Conversely, when the abbreviation “IE” (“insufficient evidence”) is used, interpretation may be informed by available PK/PD data or ECOFFs (EUCAST 2024).
Therefore, due to the lack of established breakpoints for P sanguinis, the MIC data obtained were interpreted according to EUCAST recommendations using non-species-specific criteria, enabling a preliminary evaluation of potential clinical significance. Both strains, PS12844 and PS1051, showed MIC values below the respective MICs for all tested agents. Formal classification of the strains’ susceptibility was not possible. A cautious interpretation indicates that the agent might be considered for therapy (Table 3).
Comparison of MIC values of six antimicrobial agents for PS12844 and PS1051 strains with the corresponding MIC values proposed by EUCAST for aerobic Gram-negative bacteria lacking breakpoints in standard EUCAST breakpoint tables to assess the microbiological activity of the agent against the species.
| Antimicrobial agent | MIC (PS12844) | MIC (PS1051) | MIC – values above which therapy with the agent should be discouraged |
|---|---|---|---|
| Ciprofloxacin | 0.032 | 0.032 | 0.25 |
| Levofloxacin | 0.064 | 0.064 | 0.5 |
| Cefotaxime | 0.016 | 0.016 | 0.5 |
| Ceftazidime | 0.064 | 0.023 | 4 |
| Imipenem | 0.006 | 0.004 | 2 |
| Meropenem | 0.002 | 0.002 | 2 |
To date, 57 species within the genus Psychrobacter have been documented (Ioannou et al. 2025). Because of its ability to endure extreme conditions, Psychrobacter is frequently linked to Antarctic and marine environments (Bonwitt et al. 2018). Many species from this genus have been identified, mainly from environmental sources and cold-blooded animals. However, two species, P. faecalis and P. pulmonis, have recently been found in warm-blooded animals, specifically in pigeon droppings (Kämpfer et al. 2002). These bacteria may also be part of the human microbiota, as P. arenosus, P. faecalis, P. phenylpyruvicus, and P pulmonis have been detected in the human gut (Ioannou et al. 2025). Although Psychrobacter species are considered rare opportunistic pathogens in humans, they have been isolated from various clinical specimens, including urine, biopsy material from brain tissue, swabs from ears, eyes, wounds or vulva, and body cavity fluids such as cerebrospinal fluid (CSF) and blood (Deschaght et al. 2012; Wirth et al. 2012; Caspar et al. 2016). Most of these isolates are from P. faecalis and P. pulmonis (Deschaght et al. 2012). Recently, clinical samples have identified a new species: Psychrobacter sanguinis (Wirth et al. 2012).
The isolation of P. sanguinis from blood cultures in two hospitalized patients highlights the emerging role of this species as a potential opportunistic pathogen, particularly in immunocompromised individuals or those with significant comorbidities.
Both patients in this study had underlying conditions that predispose them to bloodstream infections: alcohol use disorder (AUD) was present in both cases. One patient had aspiration pneumonia with multi-organ failure, while the other had acute kidney injury (AKI) related to benign prostatic hyperplasia (BPH). The lung diseases involved chronic pulmonary conditions, pulmonary hypertension, and grade 2 hyaline membrane syndrome, which have also been reported in several studies as risk factors for patients with Psychrobacter infections (Gini 1990; Stepanović et al. 2007; Kumaria et al. 2022). Furthermore, the range of pathogens causing pneumonia in alcohol abusers is somewhat broader and more virulent than in non-abusers, as alcohol impairs host defense mechanisms (Happel 2013). The presence of P. sanguinis in aerobic blood cultures, alongside coagulase-negative staphylococci (CoNS), raises questions about the clinical significance of P. sanguinis. Although its role as a true bloodstream pathogen cannot be definitively confirmed, its repeated isolation from blood samples suggests the possibility of secondary bacteremia or an underestimated pathogenic role in polymicrobial infections.
The potential for P. sanguinis to cause serious infections has been previously documented, including bacteremia, wound infections, and meningitis (Wirth et al. 2012; Le Guern et al. 2013; Lim et al. 2017; Bonwitt et al. 2018; Goh et al. 2020). Notably, a case of P. sanguinis cellulitis and wound infection following marine exposure was reported, suggesting that environmental exposure might contribute to its transmission (Bonwitt et al. 2018). However, in this study, both patients had no reported exposure to aquatic environments, indicating that P. sanguinis may be part of the hospital microbiome or an underrecognized component of human-associated flora, especially in patients with predisposing factors.
Despite their presence in human samples, the precise role of these pathogens in human infections remains unclear because of the limited number of studies and available data.
Accurate identification of P. sanguinis remains difficult because of its Gram-variable morphology, which can be misleading in Gram staining. In this study, Gram-stained smears showed both Gram-positive cocci and Gram-variable coccobacilli, potentially leading to misinterpretation as polymicrobial contamination or misidentification in routine clinical microbiology procedures.
The appearance of these bacterial colonies on blood agar is quite distinctive; however, it is noteworthy that while other researchers have shown the growth of Psychrobacter only on blood-enriched media, strains isolated in the present study have also grown as small, transparent colonies on MacConkey agar (Wirth et al. 2012).
Furthermore, identifying these non-fermentative bacteria biochemically can be difficult, partly because some species show little biochemical activity or grow slowly, and because certain taxa are not included in many commercial identification system databases. Misclassification with Neisseria species is common due to their phenotypic similarities (Gini 1990).
Accurately identifying P. sanguinis through phenotypic methods is difficult, so MALDI-TOF MS and 16S rRNA sequencing are crucial tools for dependable species-level identification.
MALDI-TOF MS is more useful for identifying microorganisms that are rarely isolated or cause challenges in standard diagnostic procedures, providing quick and reliable species-level identification with scores above 2.0. However, 16S rRNA sequencing was necessary to confirm species identification, as previous reports indicate that closely related Psychrobacter species, such as Psychrobacter phenylpyruvicus, Psychrobacter raelei, Psychrobacter arenosus, or Psychrobacter lutiphocae, can be misidentified using MALDI-TOF MS alone. The GenBank sequence analysis showed 99.71-100% similarity to reference P. sanguinis strains, supporting its identification and emphasizing the importance of molecular methods in cases involving rare or atypical pathogens (Seng et al. 2013; Bielec et al. 2025).
Currently, there are no established treatment protocols for Psychrobacter infections. Until antimicrobial susceptibility results are available, therapeutic approaches generally depend on empirical treatment. Psychrobacter sanguinis has previously been described as broadly susceptible, with resistance to vancomycin, penicillin, aminopenicillins, and macrolides reported in only a few cases (Ioannou et al. 2025). Third-generation cephalosporins seem to be the most effective option for managing severe Psychrobacter infections, as these bacteria are generally susceptible to this class of antibiotics.
Both P. sanguinis strains were susceptible to all tested antimicrobials. Both patients responded to ceftriaxone (2 grams IV once daily). Unfortunately, the patient infected with strain PS12844 died from complications during multi-organ failure. These findings confirm that P. sanguinis may not be intrinsically multidrug-resistant, but it can persist in bloodstream infections under favorable conditions. Nevertheless, to prevent a potentially fatal outcome, aggressive antimicrobial treatment is recommended in cases of systemic infection.
Although P. sanguinis was identified in both cases, its exact role in disease pathogenesis remains unclear. Key limitations of this study include the absence of whole-genome sequencing (WGS), which could have revealed resistance mechanisms and virulence factors (Hamid et al. 2025). Additionally, the polymicrobial nature of the infections complicated efforts to determine whether P. sanguinis was a true pathogen or an opportunistic colonizer. Because of the retrospective approach and the rarity of P. sanguinis isolation, the available epidemiological data were limited. The patients were hospitalized three months apart in different units with no known contact, and no clear source or transmission route could be identified.
Additionally, molecular typing methods were not conducted, which could have offered insights into the genetic relatedness of the isolates and transmission patterns. The only shared factor between the two patients was a history of chronic alcohol use, which may have increased their susceptibility to infection, though this connection remains hypothetical. Future research should focus on genomic analysis and environmental sources of P. sanguinis to determine its potential as an emerging hospital-acquired pathogen. Furthermore, case series and surveillance studies are needed to assess its actual clinical significance and possible transmission routes in healthcare settings.
According to published data, the cases described are another series of bloodstream infections caused by P. sanguinis reported in Poland this year (Bielec et al., 2025). At the time of manuscript submission, no other cases of P. sanguinis isolation had been recorded at the District Hospital in Limanowa, emphasizing its extraordinary rarity in clinical practice.
This study adds to the growing evidence that P. sanguinis may act as an opportunistic pathogen in hospitalized patients with underlying medical conditions. Its appearance in blood cultures calls for increased alertness among clinicians and microbiologists. Molecular identification techniques, such as MALDI-TOF MS and 16S rRNA sequencing, are crucial for precise detection, because traditional biochemical methods often lack reliability. More research is needed to understand its mechanisms of pathogenicity, resistance features, and possible role in hospital-acquired infections. Additionally, greater awareness and systematic reporting of such rare isolates are vital for better understanding their clinical significance and for developing evidence-based treatment guidelines for infections caused by P. sanguinis.